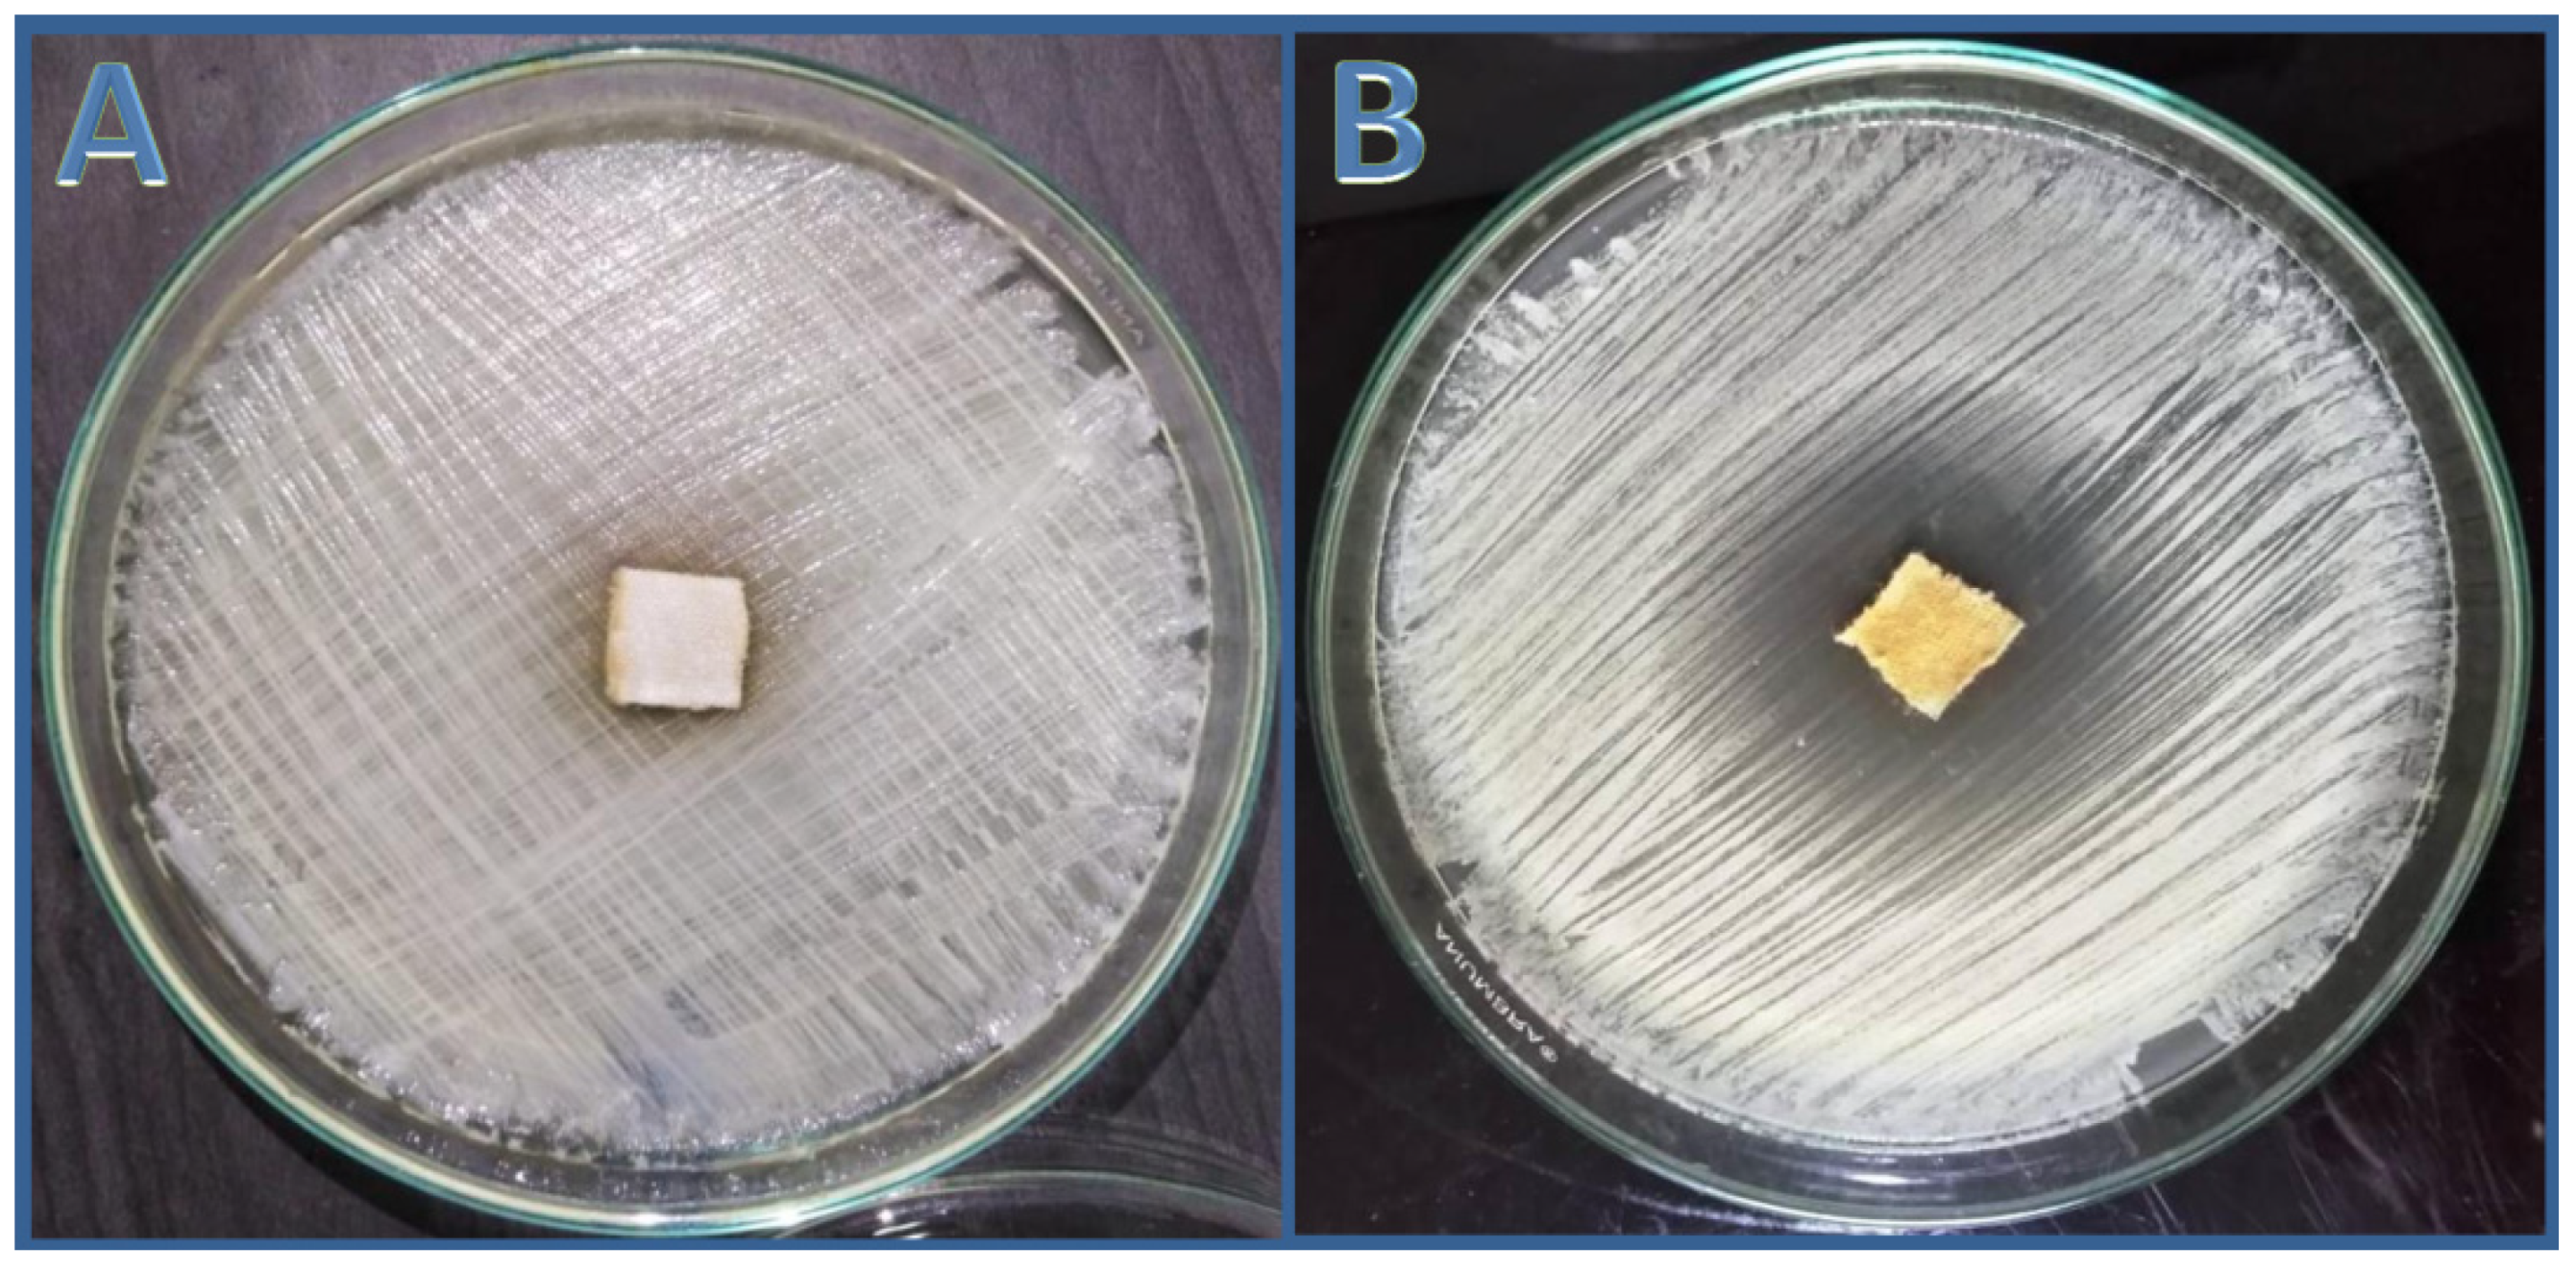
Antibiotics 11 00327 g006

Exploring the Antifungal Activity and Action of Saussurea costus Root Extracts against Candida albicans and Non-albicans Species
Abstract
1. Introduction
2. Materials and Methods
2.1. Plant Collection, Identification and Preparation
2.2. Crude Extracts Preparation and Fractionation Procedures
2.3. Standard Candida Strains
2.4. Isolation and Identification of Clinical Isolates
2.5. Screening of Anticandidal Activity
2.6. Scanning Electron Microscopy (SEM)
2.7. Chromatographic Fractionation of the n-Hexane Extract of S. costus
2.7.1. Thin Layer Chromatography
2.7.2. Thin Layer Chromatography-Direct Bioautographic (TLC-DB) Assay
2.7.3. Flash Chromatography Separation
2.7.4. Gas Chromatography–Mass Spectrometry (GC/MS) Analysis
2.7.5. Infrared Spectra
2.8. Anticandidal Action of Cotton Fabric Wound Dressings Treated with nhhE of S. costus
2.9. Statistical Analysis
3. Results
3.1. Extraction and Fractionation
3.2. Candida Species Identification
3.3. Anticandidal Activity of Saussurea costus Root Extracts
3.4. Scanning Electron Microscopy (SEM)
3.5. Chromatographic Fractionation of Anticandidal Substances of Crude n-Hexane Extract
3.5.1. Thin-Layer Chromatography (TLC)
3.5.2. Thin Layer Chromatography-Direct Bioautography (TLC-DB)
3.5.3. Purification and Identification of the Anticandidal Compounds
3.5.4. GC/MS Analysis
3.5.5. Characterization of the Isolated Compound
3.6. Assessment of Anticandidal Activity of n-Hexane Extract Using Cotton Wound Dressing
4. Discussion
5. Conclusions
Supplementary Materials
Author Contributions
Funding
Institutional Review Board Statement
Informed Consent Statement
Data Availability Statement
Conflicts of Interest
Appendix A



References
- Ciurea, C.N.; Kosovski, I.B.; Mare, A.D.; Toma, F.; Pintea-Simon, I.A.; Man, A. Candida and Candidiasis—Opportunism Versus Pathogenicity: A Review of the Virulence Traits. Microorganisms 2020, 8, 857. [Google Scholar] [CrossRef] [PubMed]
- Silva, S.; Rodrigues, C.F.; Araújo, D.; Rodrigues, M.E.; Henriques, M. Candida species biofilms’ antifungal resistance. J. Fungi 2017, 3, 8. [Google Scholar] [CrossRef] [PubMed]
- Singh, D.K.; Tóth, R.; Gácser, A. Mechanisms of pathogenic Candida species to evade the host complement attack. Front. Cell. Infect. Microbiol. 2020, 10, 94. [Google Scholar] [CrossRef] [PubMed]
- Makanjuola, O.; Bongomin, F.; Fayemiwo, S.A. An update on the roles of non-albicans Candida species in vulvovaginitis. J. Fungi 2018, 4, 121. [Google Scholar] [CrossRef]
- Casadevall, A.; Pirofski, L.-A. A therapeutic vaccine for recurrent vulvovaginal candidiasis. Clin. Infect. Dis. 2018, 66, 1937–1939. [Google Scholar] [CrossRef]
- Clancy, C.J.; Nguyen, M.H. Diagnosing invasive candidiasis. J. Clin. Microbiol. 2018, 56, e01909-17. [Google Scholar] [CrossRef]
- Farhan, M.A.; Moharram, A.M.; Salah, T.; Shaaban, O.M. Types of yeasts that cause vulvovaginal candidiasis in chronic users of corticosteroids. Med. Mycol. 2019, 57, 681–687. [Google Scholar] [CrossRef]
- Church, N.A.; McKillip, J.L. Antibiotic resistance crisis: Challenges and imperatives. Biologia 2021, 76, 1535–1550. [Google Scholar] [CrossRef]
- Denning, D.W. Echinocandin antifungal drugs. Lancet 2003, 362, 1142–1151. [Google Scholar] [CrossRef]
- Salazar, S.B.; Simões, R.S.; Pedro, N.A.; Pinheiro, M.J.; Carvalho, M.F.N.; Mira, N.P. An overview on conventional and non-conventional therapeutic approaches for the treatment of candidiasis and underlying resistance mechanisms in clinical strains. J. Fungi 2020, 6, 23. [Google Scholar] [CrossRef]
- O’Leary, R.-A.; Einav, S.; Leone, M.; Madách, K.; Martin, C.; Martin-Loeches, I. Management of invasive candidiasis and candidaemia in critically ill adults: Expert opinion of the European society of anaesthesia intensive care scientific subcommittee. J. Hosp. Infect. 2018, 98, 382–390. [Google Scholar] [CrossRef] [PubMed]
- Manirujjaman, M.; Collet, T. Antimicrobial and anti-inflammatory activities of australian native plants in the context of wound healing: A review. Biologia 2021, 76, 993–1004. [Google Scholar] [CrossRef]
- Barrero, A.F.; Oltra, J.E.; Álvarez, M.; Raslan, D.S.; Saúde, D.A.; Akssira, M. New sources and antifungal activity of sesquiterpene lactones. Fitoterapia 2000, 71, 60–64. [Google Scholar] [CrossRef]
- Kamala, A.; Middha, S.K.; Karigar, C.S. Plants in traditional medicine with special reference to Cyperus rotundus L.: A review. 3 Biotech 2018, 8, 1–11. [Google Scholar] [CrossRef] [PubMed]
- Panigrahy, S.K.; Bhatt, R.; Kumar, A. Targeting type II diabetes with plant terpenes: The new and promising antidiabetic therapeutics. Biologia 2021, 76, 241–254. [Google Scholar] [CrossRef]
- Karpiński, T.M.; Ożarowski, M.; Seremak-Mrozikiewicz, A.; Wolski, H.; Adamczak, A. Plant Preparations and Compounds with Activities against Biofilms Formed by Candida spp. J. Fungi 2021, 7, 360. [Google Scholar] [CrossRef]
- Abdallah, E.M.; Qureshi, K.A.; Ali, A.; Elhassan, G.O. Evaluation of some biological properties of Saussurea costus crude root extract. Biosci. Biotechnol. Res. Commun. 2017, 10, 601–611. [Google Scholar] [CrossRef]
- Alshubaily, F.A. Enhanced antimycotic activity of nanoconjugates from fungal chitosan and Saussurea costus extract against resistant pathogenic Candida strains. Int. J. Biol. Macromol. 2019, 141, 499–503. [Google Scholar] [CrossRef]
- Trease, G.; Evans, W.; Evans, D. Volatile oils and resins. Pharmacognosy 1996, 14, 255–292. [Google Scholar]
- Zhang, Q.W.; Lin, L.G.; Ye, W.C. Techniques for extraction and isolation of natural products: A comprehensive review. Chin. Med. 2018, 13, 1–26. [Google Scholar] [CrossRef]
- Ray-Ghosh, R.; Haldar, P.; Chatterjee, M. Characterization and antifungal susceptibility profile of Candida species isolated from Candiduria cases in a tertiary care hospital, Kolkata. Int. J. Curr. Microbiol. App. Sci. 2019, 8, 1079–1085. [Google Scholar] [CrossRef]
- Muthamil, S.; Pandian, S.K. Inhibitory effect of Murrayakoenigii against Candida albicans virulence and biofilm development. Biologia 2016, 71, 256–264. [Google Scholar] [CrossRef]
- Tayel, A.A.; Moussa, S.; El-Tras, W.F.; Knittel, D.; Opwis, K.; Schollmeyer, E. Anticandidal action of fungal chitosan against Candida albicans. Int. J. Biol. Macromol. 2010, 47, 454–457. [Google Scholar] [CrossRef] [PubMed]
- Staniszewska, M.; Bondaryk, M.; Swoboda-Kopec, E.; Siennicka, K.; Sygitowicz, G.; Kurzatkowski, W. Candida albicans morphologies revealed by scanning electron microscopy analysis. Braz. J. Microbiol. 2013, 44, 813–821. [Google Scholar] [CrossRef]
- Demirci, B.; Toyota, M.; Demirci, F.; Dadandi, M.Y.; Baser, K.H.C. Anticandidal pimaradienediterpene from Phlomis essential oils. Comptes Rendus Chim. 2009, 12, 612–621. [Google Scholar] [CrossRef]
- İşcan, G.; Kïrïmer, N.; Kürkcüoǧlu, M.; Başer, H.C.; Demirci, F. Antimicrobial screening of Menthapiperita essential oils. J. Agric. Food Chem. 2002, 50, 3943–3946. [Google Scholar] [CrossRef]
- Tayel, A.A.; Moussa, S.H.; El-Tras, W.F.; Elguindy, N.M.; Opwis, K. Antimicrobial textile treated with chitosan from Aspergillus niger mycelial waste. Int. J. Biol. Macromol. 2011, 49, 241–245. [Google Scholar] [CrossRef]
- Naik, A.; Prajapat, P.; Krishnamurthy, R.; Pathak, J.M. Assessment of genetic diversity in Costus pictus accessions based on RAPD and ISSR markers. 3 Biotech 2017, 7, 70. [Google Scholar] [CrossRef]
- Khan, M.M. Sahih Al-Bukhari, Arabic-English Translation; KitabBhavan: New Delhi, India, 1984. [Google Scholar]
- Kamil, M. Sassurealappa: A Scientific Review; Herbal medicine in India; Springer: Delhi, India, 2020; pp. 215–221. [Google Scholar]
- Subramani, R.; Narayanasamy, M.; Feussner, K.D. Plant-derived antimicrobials to fight against multi-drug-resistant human pathogens. 3 Biotech 2017, 7, 1–5. [Google Scholar] [CrossRef]
- Deabes, M.M.; Fatah, A.-E.; Sally, I.; Salem, S.H.E.; Naguib, K.M. Antimicrobial activity of bioactive compounds extract from Saussurea costus against food spoilage microorganisms. Egypt. J. Chem. 2021, 64, 9–10. [Google Scholar] [CrossRef]
- Kagan, I.; Hammerschmidt, R. Arabidopsis ecotype variability in camalexin production and reaction to infection by Alternariabrassicicola. J. Chem. Ecol. 2002, 28, 2121–2140. [Google Scholar] [CrossRef] [PubMed]
- Asokkumar, K.; Ramachandran, S. Herb-Drug Interactions: Focus on Adverse Drug Reactions and Pharmacovigilance of Herbal Medicines; Herbal Medicine in India; Springer: Berlin/Heidelberg, Germany, 2020; pp. 547–571. [Google Scholar]
- Sülsen, V.P.; Martino, V.S. Sesquiterpene Lactones. Advances in their Chemistry and Biological Aspects; Springer: Cham, Switzerland, 2018. [Google Scholar]
- Singh, B.; Sharma, R.A. Plant terpenes: Defense responses, phylogenetic analysis, regulation and clinical applications. 3 Biotech 2015, 5, 129–151. [Google Scholar] [CrossRef] [PubMed]
- Gwari, G.; Bhandari, U.; Andola, H.C.; Lohani, H.; Chauhan, N. Volatile constituents of Saussurea costus roots cultivated in Uttarakhand Himalayas, India. Pharmacogn. Res. 2013, 5, 179. [Google Scholar]
- Laurella, L.C.; Cerny, N.; Bivona, A.E.; Sánchez Alberti, A.; Giberti, G.; Malchiodi, E.L.; Martino, V.S.; Catalan, C.A.; Alonso, M.R.; Cazorla, S.I.; et al. Assessment of sesquiterpene lactones isolated from Mikania plants species for their potential efficacy against Trypanosoma cruzi and Leishmania sp. PLoS Negl. Trop. Dis. 2017, 11, e0005929. [Google Scholar] [CrossRef]
- Moreira, I.C.; Lago, J.H.G.; Young, M.C.M.; Roque, N.F. Antifungal aromadendranesesquiterpenoids from the leaves of Xylopiabrasiliensis. J. Braz. Chem. Soc. 2003, 14, 828–831. [Google Scholar] [CrossRef]
- Nadda, R.K.; Ali, A.; Goyal, R.C.; Khosla, P.K.; Goyal, R. Aucklandia costus (syn. Saussurea costus): Ethnopharmacology of an endangered medicinal plant of the Himalayan region. J. Ethnopharmacol. 2020, 27, 113199. [Google Scholar] [CrossRef]
- Alves, J.C. A review on the chemistry of eremanthine: A sesquiterpene lactone with relevant biological activity. Org. Chem. Int. 2011, 2011, 170196. [Google Scholar] [CrossRef][Green Version]
- Srour, J.; Berg, E.; Mahltig, B.; Smolik, T.; Wollenberg, A. Evaluation of antimicrobial textiles for atopic dermatitis. J. Eur. Acad. Dermatol. Venereol. 2019, 33, 384–390. [Google Scholar] [CrossRef]
- Zida, A.; Bamba, S.; Yacouba, A.; Ouedraogo-Traore, R.; Guiguemdé, R.T. Anti-Candida albicans natural products, sources of new antifungal drugs: A review. J. Mycol. Med. 2017, 27, 1–19. [Google Scholar] [CrossRef]
- Hsu, H.; Sheth, C.C.; Veses, V. Herbal extracts with antifungal activity against Candida albicans: A systematic review. Mini Rev. Med. Chem. 2021, 21, 90–117. [Google Scholar] [CrossRef]
- Criseo, G.; Scordino, F.; Romeo, O. Current methods for identifying clinically important cryptic Candida species. J. Microbiol. Methods 2015, 111, 50–56. [Google Scholar] [CrossRef] [PubMed]
- Vazquez, J.A. Combination antifungal therapy against Candida species: The new frontier-are we there yet? Med. Mycolo. 2003, 41, 355–368. [Google Scholar] [CrossRef] [PubMed]

| Solvent Mixture | % (v/v) |
|---|---|
| petroleum ether: ethyl acetate | 9:1 |
| petroleum ether: ethyl acetate | 10:1 |
| petroleum ether: ethyl acetate | 9.3:0.7 |
| n-hexane: ethyl acetate | 6.7:3.3 |
| petroleum ether: dichloromethane: ethyl acetate | 7:2.3:0.7 |
| Code No. | Name of the Standard Strains Candida and Isolates | Diameter of Zone of Inhibition (mm) | Standard Antibiotic (Fluconazole) | |||
|---|---|---|---|---|---|---|
| n-Hexan | Dichloromethane | |||||
| Zone of Inhibition | MIC (mg/mL) | Zone of Inhibition | MIC (mg/mL) | |||
| ATCC 10231 | C. albicans | 13 ± 2 | 1 | 10 ± 1 | 3 | 10 ± 2 |
| MH 445555 | C. tropicalis | 12 ± 2 | 1 | 0.9 ± 1 | 4 | 15 ± 2 |
| MH 445556 | C. parapsilosis | 13 ± 2 | 1 | 11 ± 2 | 3.5 | 13 ± 2 |
| Biochemical ID | C. pseudotropicalis | 15 ± 2 | 0.25 | 0.8 ± 1 | 4.5 | 09 ± 2 |
| Biochemical ID | C. guillimondii | 14 ± 1 | 1 | 12 ± 1 | 3 | 12 ± 2 |
| * W1 | (C. tropicalis) | 12 ± 2 | 1 | 10 ± 1 | 3 | 11 ± 2 |
| W2 | (C. parapsilosis) | 10 ± 1 | 1.5 | 8 ± 1 | 3 | - |
| ** V1 | (C. parapsilosis) | 11 ± 2 | 1 | 10 ± 1 | 3.5 | 12 ± 2 |
| V2 | (C. albicans) | 13 ± 2 | 1.5 | 10 ± 1 | 4 | - |
| *** U1 | (C. albicans) | 12 ± 2 | 1 | 10 ± 1 | 3 | 13 ± 2 |
| U2 | (C. albicans) | 11 ± 2 | 1.5 | 10 ± 1 | 4 | 12 ± 2 |
| U3 | (C. albicans) | 12 ± 3 | 1 | 11 ± 1 | 3.5 | 14 ± 2 |
| U4 | (C. albicans) | 13 ± 2 | 1 | 10 ± 1 | 3 | 13 ± 2 |
| U5 | (C. albicans) | 18 ± 2 | 0.2 | 12 ± 2 | 3 | 17 ± 2 |
| U6 | (C. albicans) | 11 ± 1 | 1 | 0.9 ± 1 | 3 | 10 ± 2 |
| U7 | (C. albicans) | 12 ± 2 | 1 | 0.9 ± 1 | 3 | 13 ± 2 |
| U8 | (C. parapsilosis) | 13 ± 2 | 1 | 11 ± 2 | 4 | 12 ± 2 |
| U9 | (C. albicans) | 17 ± 2 | 0.2 | 12 ± 2 | 3 | 13 ± 2 |
| U10 | (C. tropicalis) | 15 ± 2 | 0.5 | 0.8 ± 1 | 4.5 | - |
| U11 | (C. pseudotropicalis) | 14 ± 1 | 0.5 | 12 ± 1 | 3 | 15 ± 2 |
| U12 | (C. guillimondii) | 14 ± 3 | 0.5 | 11 ± 2 | 3 | 13 ± 2 |
| U13 | (C. albicans) | 17 ± 1 | 0.2 | 0.8 ± 1 | 3 | - |
| U14 | (C. glabrata) | 11 ± 1 | 1.5 | 0.8 ± 1 | 4 | 12 ± 2 |
| U15 | (C. tropicalis) | 14 ± 2 | 0.5 | 11 ± 1 | 4 | 13 ± 2 |
| U16 | (C. albicans) | 11 ± 1 | 1.5 | 0.8 ± 1 | 4.5 | 12 ± 2 |
| U17 | (C. parapsilosis) | 13 ± 2 | 1 | 10 ± 1 | 3 | 14 ± 2 |
| U18 | (C. parapsilosis) | 12 ± 2 | 1 | 10 ± 1 | 4.5 | 13 ± 2 |
| U19 | (C. parapsilosis) | 12 ± 2 | 1 | 10 ± 1 | 4 | 11 ± 2 |
| U20 | (C. glabrata) | 12 ± 3 | 0.5 | 11 ± 1 | 3 | 10 ± 2 |
| U21 | (C. parapsilosis) | 13 ± 2 | 0.5 | 10 ± 1 | 3 | 12 ± 2 |
| U22 | (C. parapsilosis) | 12 ± 2 | 1 | 10 ± 1 | 4 | 11 ± 2 |
| U23 | (C. albicans) | 10 ± 1 | 1.5 | 8 ± 1 | 3.5 | 09 ± 2 |
| U24 | (C. albicans) | 18 ± 2 | 0.2 | 12 ± 2 | 3 | 16 ± 2 |
| U25 | (C. albicans) | 11 ± 1 | 1.5 | 0.9 ± 1 | 4 | 10 ± 2 |
| U26 | (C. glabrata) | 12 ± 2 | 1 | 0.9 ± 1 | 3 | 13 ± 2 |
| Compound Name | Retention Time (min) | Molecular Formula | m/z Fragments a | Peak Area (%) |
|---|---|---|---|---|
| α-Selinene | 21.75 | C15H24 | 204, 105 *, 107, 93, 79 | 02.27 |
| Caryophyllene oxide | 24.07 | C15H24O | 93, 79, 43, 41 * | 02.12 |
| 11,14,17-Eicosatrienoic acid methyl ester | 25.92 | C21H36O2 | 79 *, 67, 55, 41 | 11.40 |
| α-Amyrin | 26.46 | C30H50O | 218 *, 203 | 00.69 |
| 8-Cedren-13-ol | 28.20 | C15H24O | 119 *, 105, 91, 41 | 03.04 |
| 1-acetyl-6-methylbenzotriazole | 29.65 | C9H9N3O | 147 *, 119, 103 | 06.27 |
| Costunolide | 29.73 | C15H20O2 | 109, 81 *, 53, 41 | 05.38 |
| cis-Lanceol | 31.76 | C15H24O | 93 *, 91, 79, 43 | 06.56 |
| Hexadecanoic acid, ethyl ester (Palmitic acid ethyl ester) | 32.47 | C18H36O2 | 101, 88 *, 43 | 00.36 |
| dehydrocostuslactone | 32.89 | C15H18O2 | 150, 91 * | 22.50 |
| 9,12-Octadecadienoic acid (Z,Z)-, methyl ester | 34.26 | C19H34O2 | 81, 67 *, 55, 41 | 00.90 |
| Ethyl linoleate | 35.42 | C20H36O2 | 95, 81, 67 *, 55 | 00.39 |
Publisher’s Note: MDPI stays neutral with regard to jurisdictional claims in published maps and institutional affiliations. |
© 2022 by the authors. Licensee MDPI, Basel, Switzerland. This article is an open access article distributed under the terms and conditions of the Creative Commons Attribution (CC BY) license (https://creativecommons.org/licenses/by/4.0/).
Share and Cite
Soliman, M.F.; Shetaia, Y.M.; Tayel, A.A.; Munshi, A.M.; Alatawi, F.A.; Alsieni, M.A.; Al-Saman, M.A. Exploring the Antifungal Activity and Action of Saussurea costus Root Extracts against Candida albicans and Non-albicans Species. Antibiotics 2022, 11, 327. https://doi.org/10.3390/antibiotics11030327
Soliman MF, Shetaia YM, Tayel AA, Munshi AM, Alatawi FA, Alsieni MA, Al-Saman MA. Exploring the Antifungal Activity and Action of Saussurea costus Root Extracts against Candida albicans and Non-albicans Species. Antibiotics. 2022; 11(3):327. https://doi.org/10.3390/antibiotics11030327
Chicago/Turabian StyleSoliman, Melad F., Youssria M. Shetaia, Ahmed A. Tayel, Alaa M. Munshi, Fuad A. Alatawi, Mohammed A. Alsieni, and Mahmoud A. Al-Saman. 2022. "Exploring the Antifungal Activity and Action of Saussurea costus Root Extracts against Candida albicans and Non-albicans Species" Antibiotics 11, no. 3: 327. https://doi.org/10.3390/antibiotics11030327
APA StyleSoliman, M. F., Shetaia, Y. M., Tayel, A. A., Munshi, A. M., Alatawi, F. A., Alsieni, M. A., & Al-Saman, M. A. (2022). Exploring the Antifungal Activity and Action of Saussurea costus Root Extracts against Candida albicans and Non-albicans Species. Antibiotics, 11(3), 327. https://doi.org/10.3390/antibiotics11030327






